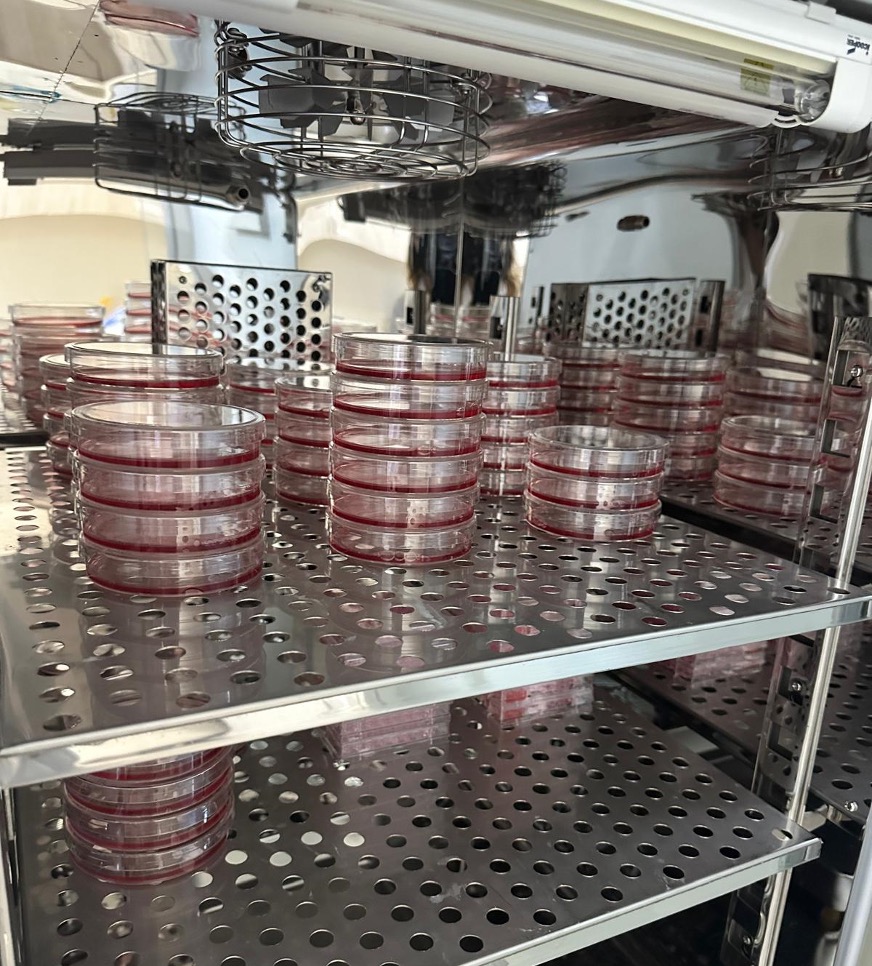
content-slider

Hakkında
Kanser Moleküler Biyolojisi Laboratuvarı’nda, bünyesinde bulunan 15 farklı kanser hücre hattı ile çalışmalar yürütülmektedir. Laboratuvar çalışmaları kapsamında dirençli hücre geliştirme protokolleri, hücre ölüm mekanizmaları ve sinyal yolaklarının araştırılması çalışmaları gerçekleştirilmektedir. Sitotoksisite testleri, Elisa testleri ve gen ekspresyonu çalışmaları yürütülmektedir. Birden fazla etken madde ile araştırmalar gerçekleştirilmektedir. Bunlar arasında farklı tedavilerde kullanılan ilaçların kanserli hücrelerde ilaç yeniden konumlandırması, bitki ekstraktları, nanopartiküller ve flavonoidlerin etkilerinin araştırılması bulunmaktadır.
Laboratuvar Sorumlusu: Prof. Dr. Esra Aydemir
Lisansüstü Öğrenciler: Serap ÖZKAYA GÜL (Doktora Öğrencisi), Beyzanur ŞİMŞEK (Doktora Öğrencisi), Fidan YILDIZ (Yüksek Lisans Öğrencisi)
Adres: Akdeniz Üniversitesi, Fen Fakültesi A Blok, Zemin Kat, No: 25
Telefon: +90 242 310 38 45
Eklenme tarihi :4.11.2022 10:42:39
Son güncelleme : 1.04.2026 08:13:24
Son güncelleme : 1.04.2026 08:13:24